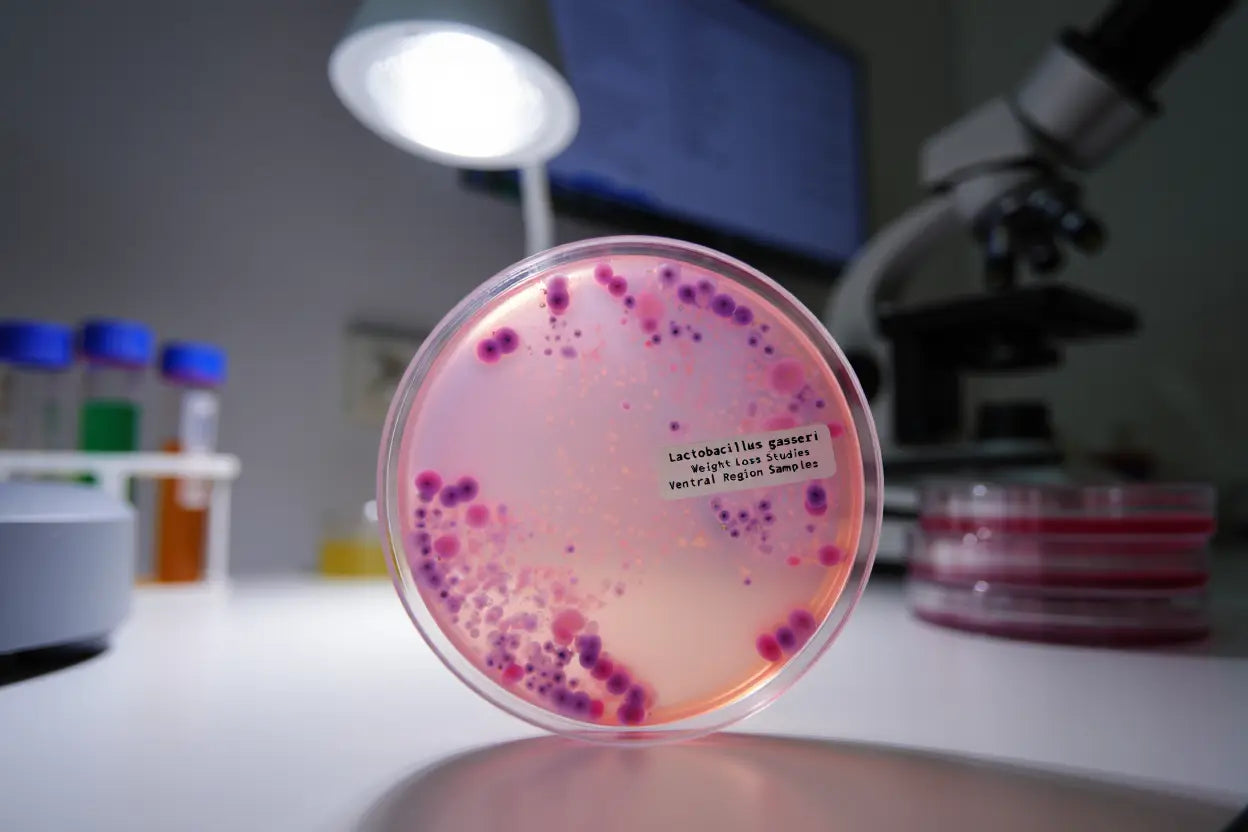
Bienfaits lactobacillus gasseri : digestion, poids et gélules

bienfaits immunité
Benefits of Lactobacillus Gasseri: Digestion, Weight, and Capsules
This Lactobacillus gasseri probiotic has recognized benefits for digestion and weight. Complete guide on capsules and their use.
Benefits of Lactobacillus Gasseri: Digestion, Weight, and Capsules
This Lactobacillus gasseri probiotic has recognized benefits for digestion and weight. Complete guide on capsules and their use.